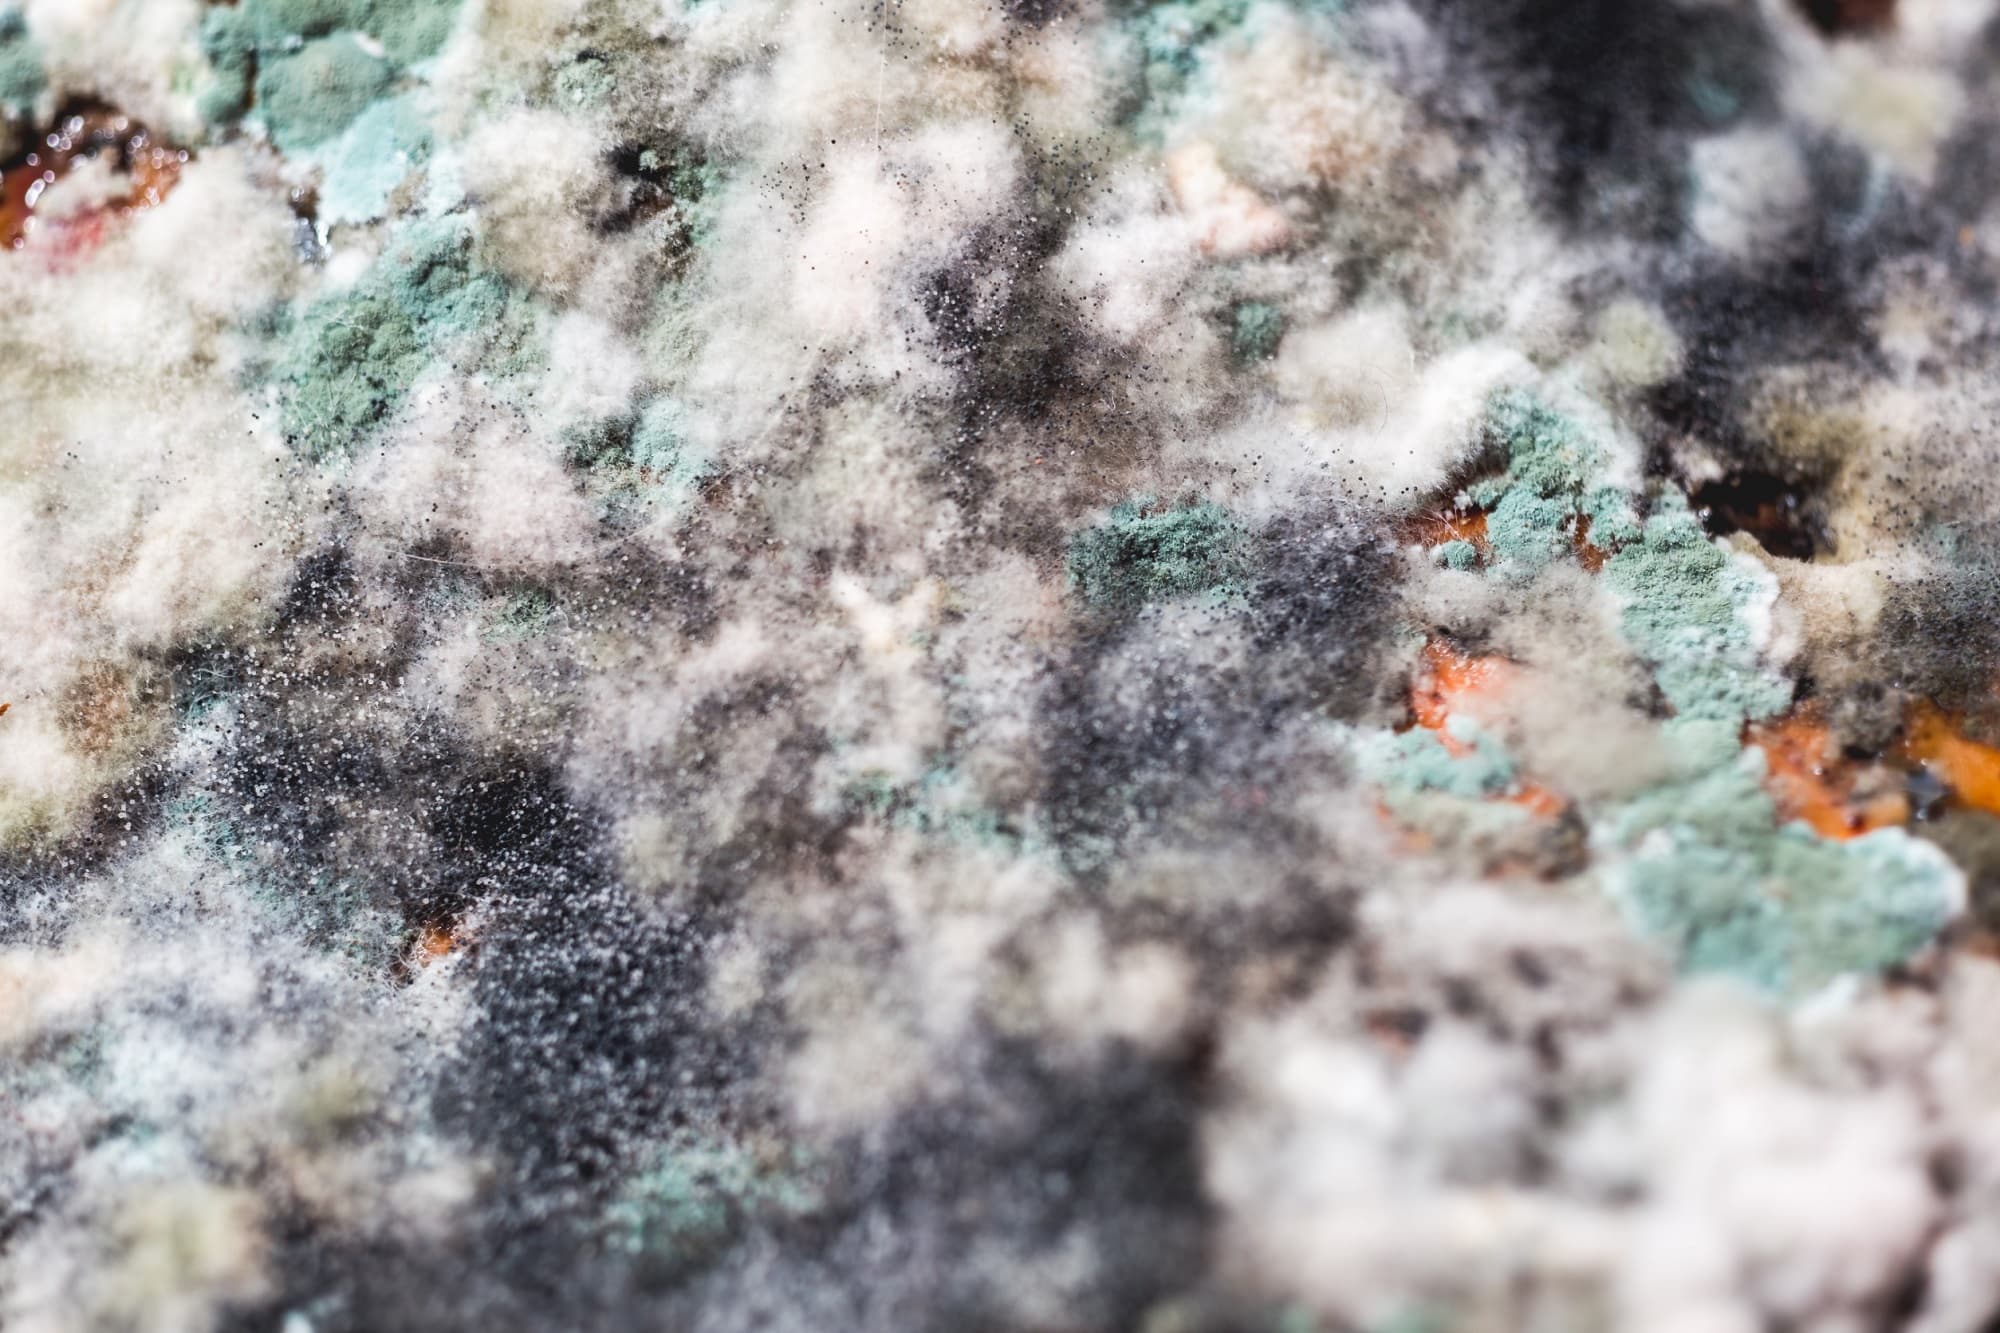
129843899_m_normal_none.jpg

A penész természetes mellékterméke a nedves környezetnek – de ez még nem jelenti azt, hogy meg kell osztanunk életterünket ezzel az egészségre veszélyes gombával. Ahelyett azonban, hogy durva vegyszerek – például a klór vagy bórax – után nyúlnál, vess be természetes módszereket.
Mutatunk pár tippet, amelyeknek köszönhetően ugyanolyan hatékonyan le tudsz
számolni a fekete foltokkal anélkül, hogy ártanál vele az egészségednek vagy a
környezetnek.
Ecet
Noha az ecet az egyik leguniverzálisabb házi
megoldás, sokan erős szaga miatt nem szeretik. A jó hír azonban, hogy hígíthatod
vízzel, vagy akár némi illóolajat is adhatsz hozzá, hogy csökkentsd a csípős aromát.
A lényeg, hogy a keveréket egyenesen a problémás felületre vidd fel! Hagyd hatni
néhány órán át, majd egy kefével alaposan mosd le.
Tanulmányok szerint a fehér
ecet a penészspórák, vírusok és baktériumok akár 80 százalékát is képes
elpusztítani.

Teafaolaj oldat
A teafaolaj, bár hatékony természetes
penészeltávolító, drágább lehet néhány más környezetbarát megoldásnál. Viszont
mindössze 2 teáskanálnyi elég belőle, amit 2 csésze vízben kell feloldanod.
Permetezd a penészspórákra, de ne öblítsd le. A teafaolajnak erős illata van,
néhány nap kell, míg elpárolog.
Citrusmag
Az ecettel és a teafaolajjal ellentétben a
citrusmag kivonatnak (például a grapefruitnak) nincs szaga, ami – lássuk be –
nagy előny. A hatékony penészölőhöz kb. 20 csepp kivonatot hígíts fel 2 csésze
vízzel, keverd össze egy szórófejes flakonban, majd permetezd közvetlenül a
penészre. Egy kis idő után leöblítheted.

Szódabikarbóna
A szódabikarbóna önmagában vagy vízzel vegyítve
is hatékonyan eltávolítja a penészt.
Oldj fel 2 rész szódabikarbónát 1 rész vízben,
majd az így kapott pasztát kend fel az érintett felületre.
Hagyd hatni egy
picit, majd dörzsöld át és töröld le egy nedves ruhával. A szódabikarbóna
természetes fertőtlenítőszer, egyben nagyon enyhe is, így kellemetlen szagok
nélkül teszi a dolgát.
Menj elébe!
A penész természetbarát ellenfeleinél még inkább
természetbarát, ha teszel azért, hogy a gomba meg se jelenhessen otthonunkban.
Szellőztess rendszeresen, amikor csak az időjárás engedi, teregess ki a
szabadban, gyakran töröld le az nedves felületeket, az olyan, sokat használt
vizes területeket pedig, mint például a zuhanyzó fala, időnként permetezd be
ecettel.
A penész természetes, de az otthonunk falain
kívül.